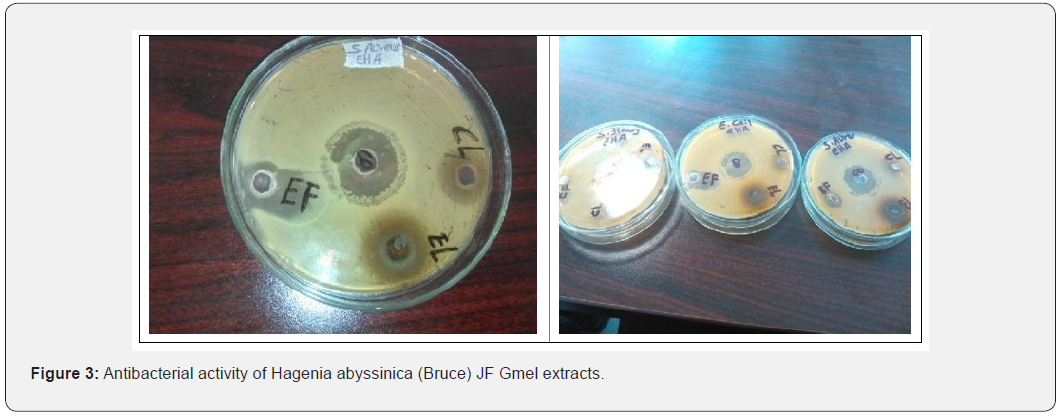
Click here to view Large Figure 3 Advances in Biotechnology & Microbiology

Antibacterial Effect of Hagenia Abyssinica (Bruce) JF Gmel Against on Selected Pathogens
Alazar Yeshitla* and Endeshaw Abatenh
Department of Biotechnology, College of Chemical and Biological, Addis Ababa Sciences and Technology University, Ethiopia
Submission: February 08, 2020; Published: March 13, 2020
*Corresponding author: Alazar Yeshitla, Department of Biotechnology, College of Chemical and Biological, Addis Ababa Sciences and Technology University, Addis Ababa, Ethiopia
How to cite this article: Alazar Y, Endeshaw A. Antibacterial Effect of Hagenia Abyssinica (Bruce) JF Gmel Against on Selected Pathogens. Adv Biotech & Micro. 2020; 15(4): 555917. DOI:10.19080/AIBM.2020.15.555917
Abstract
Hagenia abyssinica (Bruce) JF Gmel is a species of flowering plant and crucial for a remedy for intestinal parasites that appeared on humans. Globally medicinal plants used as alternative drugs acquired from plants naturally. This study was conducted to investigate the antimicrobial activities of different solvent extracts of Hagenia abyssinica (Bruce) JF Gmel flowers and leaves against 3 selected pathogenic microorganisms. At the same time to conserve it. Field surveys were incorporated to assess owns herbal medicinal values. The Experimental study design was performed/implemented, Microbiology laboratory of AASTU. Agar well diffusion method was used to In vitro bioassay. It was detected by measuring the zone of inhibition (excluding the diameter of wells) that appeared after overnight incubated at 370C. Ethanol and chloroform extracts showed significant inhibitory activity against Escherichia coli, Shigella flexneri, and Staphylococcus aureus. Ethanol flower extract was the highest impact on all test organisms (5mm). Ethanol leaf extract was the smallest effect against Shigella flexneri (2mm). Other studies already undertaken in Ethiopia and Brazil revealed that different medicinal plants have unique antimicrobial capacity or efficiency. It was conserved because it has implications for example to extraordinary research purpose and to save nature. Medicinal plants are fruitful to treat human and animal ailments. This study showed that different solvent extracts have strengths and weaknesses regarding inhibiting the growth of gram-negative species. Hagenia abyssinica (Bruce) JF Gmel were screened for an antimicrobial agent. The finding could reflect the areal part has a bioactive constitute. Determination of minimum inhibitory concentrations and full screening of phytochemicals were mandatory for extra advantages.
Keywords:Antibacterial; Crude extracts; Flower; Leaf; In vitro
Introduction
Hagenia abyssinica (Bruce) JF Gmel is a species of flowering plant and a native to the high-elevation Afromontane regions of central and eastern Africa. It is a multipurpose dioecious tree used as consumption, prevention and treatment of disease particularly a remedy for intestinal parasites particularly against Cestodes-Tapeworm in humans. Besides being a source of medicine, it has been utilized for various other purposes such as construction, furniture, fuel wood, and soil fertility management [1-4]. Almost all regions of the world, peoples are depending on traditional knowledge and medicinal plants to meet some of their primary health care needs. Medicinal plants have active biochemical compounds that function to the inhibit growth of pathogenic organisms [5,10]. Traditional medicinal plants are responsible for the treatment and preventive practice since prehistoric times. Local researchers focus on the identification and documentation of traditional herbal plants, but its potentials are scientifically uncharacterized [4,9]. Former studies do not provide sufficiently detailed information on the antibacterial profile of Hagenia abyssinica (Bruce) JF Gmel This paper may address the untouched features of scientific communities. Nowadays, Antimicrobial resistance has become a global concern. Drug scientists provide special attention to innovative plant-based antimicrobials instead of synthetic substances to combat pathogenic diseases. Natural products are considered as effective sources of novel compounds and termed as a core competitive advantage. There is a need to develop safe, highly effective and broad-spectrum antimicrobial agents that possess potent biological activities with a novel mode of action [11-21]. The number of diseases that infect humans not only increasing throughout the world but also the frequency of life-threatening infections caused by pathogenic organisms is also increasing worldwide. In recent years, antimicrobial characteristics of herbal plants are announced from various zones of continents. Normally, it is predicted that extracts exhibited target sites other than those used by antibiotics will be effective against multiple drug-resistant microbial pathogens [10].
The spread of drug-resistant microorganisms is a big threat to successful therapy of microbial diseases especially in children [15]. E.coli and Shigella are developing increasing antibiotic resistance. Usually taken antibiotics also cause diarrheal and antibiotic-associated diarrhea is the most common adverse effect of treatment with general antibiotics. Increased prevalence of resistant bacteria still now a scientific and political issue, together with absence and unfair cost of new generation drugs has escalated acute and chronic infection. Surprisingly, medicinal plants are used for the treatment of medical and clinical pathogenic bacteria. Infectious diseases of bacterial origins (Salmonella Spp., and Shigella Spp.) represent the major cause of morbidity and mortality in developing countries [22-26]. However, many Ethiopian medicinal plants are still waiting for scientific validation of their anti-microbial potentials [2]. Then searching for a new antibacterial agent is from medicinal plants is even more urgent in Ethiopia. The first aim of the study was to evaluate the in vitro antibacterial assay of the crude extracts of Hagenia abyssinica (Bruce) J.F. Gmel against Escherichia coli, Shigella flexneri and Staphylococcus aureus. Finally, this typical genetic resource was conserved via the ex-situ approach.
Materials and Methods
Study area
A preliminary field survey was carried out around Kotebe Metropolitan University All laboratory activities were conducted in Microbiology Laboratory, Addis Ababa Science and Technology University (AASTU) from April 1 to May 20, 2015 (Figure1). Addis Ababa is the Federal Capital of Ethiopia and a Chartered City, having three layers of Government City Government at the top, 10 Sub City Administrations in the Middle, and 99 Kebele Administrations at the bottom. It is located between 8055’ and 9005’ North Latitude and between 38040’ and 38050’ East Longitude. The total land area is covering 54,000 hectares. The date of establishment was November 1887 by Emperor Menelik II and Empress Taitu. The estimated population is More than 3 million. Its average elevation is 2,500 meters above sea level, and hence has a fairly favorable climate and moderate weather conditions. Addis Ababa is the capital city of Ethiopia, the seat of the African Union (AU) and the United Nations Economic Commissions for Africa (UNECA).

Research design
A cross-sectional based and in vitro experimental design was adopted to conduct the study. Hagenia abyssinica (Bruce) JF Gmel collected and conserved for sustainable utilization [4 ,17].
Sample collection
The samples were upper plant parts. Representative informants were asked to share their background, knowledge, and experience about Hagenia abyssinica (Bruce) JF Gmel formally. Effective communication occurred on it used part, utilization, means of application, mode of preparation, dosage and extra purposes seen in their life. Respondents were Semi-structured interviewed during their operation time to know the status of the species, drivers, barriers, management efforts and conservational activities taken place in the study area but excluded here.
Sample size and sampling technique
Twelve Hagenia abyssinica (Bruce) JF Gmel a species were selected for treatment of ailments caused by bacterial agents and also for planting. Purposive sampling was implemented with twenty key informants, such as elderly and traditional healers. They already had traditional and indigenous knowledge about it [4].
Plant material
Plant specimens were gathered from the Yeka sub-city around the Koteb site. In the study area, the vernacular name was termed as Kosso in the Amharic language. Hagenia abyssinica (Bruce) JF Gmel specimens were collected, pressed, submitted, identified and confirmed by a taxonomist and herbal experts. General authentications were carried out morphologically in National Herbarium, Addis Ababa University [4]. To ensure the desired plant species from the side of informants, Morphological identification key or attributes had inclusive (Figure 2).

Preparation of crude extracts
The raw plant parts (flower and leaf) were collected from their natural habitat in plastic bags and washed with distilled water to remove unnecessary particles like debris and dust. It was dried under shade at room temperature for about a week. The airdried plant materials were ground using a grinder or commercial blender to obtain a homogenous powder. The powders of each plant sample were weighed using the precision standard electronic balance. 1 gram of flower sample was immersed in each of three conical flasks containing 100ml distilled water, 95% ethanol, and chloroform solvent. The same procedure used for leaf also. Soaked samples were stayed for 72 hours with shaking with an orbital shaker (Gemmy Industrial Corporation, VRN-480) at 100 rpm and an occasional manual stirring with a glass rod. After 3 days, the macerates of each plant were filtered in separate flasks by using standard filter paper Whatman number 1. The residues after the filtration process were discarded while the filtrate parts were introduced to a vacuum rotary evaporator (GM- 0.3111, 30 letter /ml ultimate vacuum 50 Mbar) machine for extraction with at 25- 35 °C temperature adjustment. In addition to this extract, solvents were allowed to evaporate by using dry oven (35 °c for forty-five minutes). The dry weight of the extracts was used to determine the concentration in mg/ml. The remains dried extract was stored in a sterile container at +4 °C refrigerator for further application [2, 7,11].
Bacterial species
The three gram-negative bacteria (E.coli, S. aures and S. flexneri strains) known to cause foodborne bacterial infection. These test microorganisms used in the present study were obtained from the Microbial culture collection, New Delhi, India. Then it kept at -80 °C until use. The Bacterial strains were reactivated by subculturing on nutrient broth (HI media) at 37 °C for 24 hr. The Purity and viability of the organisms were checked by culturing nutrient agar (HI media) at 37 °C overnight in the presence of oxygen. It became maintained on nutrient agar slant at 4 °C for further activity. The selection criteria of bacterial were based on their contingency pattern of multi-drug resistance, cytotoxicity, and accessibility.
Antibacterial Assay
Muller Hinton agar was used for the antimicrobial tests whereas Nutrient agar (HIMEDIA Laboratories) was also used for routine stock cultures and sub-culturing. The medium was prepared plus autoclaved (121 °C and pressure of 15 pounds/ square inch /for 15 minutes) then cooled at 45-50 °C. Antibacterial activity of potential plant extract against bacterial pathogens by agar well diffusion assay technique (Figure 3). Fresh plate culture of 0.5 Mc Farland turbidity standard which corresponds to approximately 1.5 × 108 CFU/ml bacterial suspensions were uniformly spread on the solidified Mueller-Hinton (HIMEDIA Laboratories) plate via sterile swab to form lawn cultures. Then, allowed to dry for about five up to ten minutes. The use of a sterile Cork borer, holes of 9 millimeters in diameter was made in the seeded agar. With the help of micropipette, 50 microliters of each of the extracts (from the concentration 100 milligrams/ml or equivalent to 1 gram/ml stock solution) were introduced into the respective wells aseptically. Antibiotic was purchased from an authorized drug store in Addis. A working solution (50𝜇g/ml) of amoxicillin was prepared from a stock solution as a positive control. The experiment was performed in triplicate. The media were kept in the biosafety cabinet for 1 hour for proper diffusion. The plates were incubated at 37 °C for 24 hours aerobically. The final results were obtained by a measured zone of inhibition with a caliper [7, 11,17].
Data analysis
The outcome of antibacterial tests was examined, recorded and analyzed by applying Microsoft spreadsheet 2010 and finally taken the averages (Table 1). The ultimate inhibition zone was interpreted in a simple table.

Discussion
The present in vitro experimental study was reviled the antibacterial effectiveness of Hagenia abyssinica (Bruce) JF Gmel extracts against the target human pathogens. It could serve for future benefits and fill the concrete gap in the area of pharmacology. The ultimate evaluation outcome showed that ethanolic flower extract was more active than other water and chloroform extracts against tested organisms. It became verified by inhibiting and treating those selected bacteria strains. This study outcome helps to decide and declare the presence of bioactive compounds or phytochemicals abundantly. Previously reported papers indicated that medicinal plants have unique and pure biochemical constitutes like Alkaloids Glycosides, Saponins, Tannins, Flavonoids, and other unknowns. Those are lead to effective antibacterial activity against clinical isolates of Shigella and Salmonella [26,27].
Crude ethanolic extracts were used for the evaluation of biological activities because ethanol can extract most of the polar and moderately polar constituents. Based on past findings, in the current demonstration ethanol has been selected as a solvent to extract active compounds from the plant products [25]. In the present study, high anti-bacterial activities were exhibited from ethanol flower extract on E.coli (5 mm). And the minimum inhibition zone was observed on leaf extract in S. flexneri strains (2 mm). However, the activities were weak, and the zones of inhibition were generally much smaller than those made by the standard. It might be vital to reducing the negative consequences of antibiotics when the target plant is optimized. This result consisted of another research in Myanmar. E. coli appeared to be most strongly affected by 95% ethanol extract of Terminalia chebula Retz., with a 17 mm diameter zone of inhibition, while the standard, chloramphenicol, had a diameter of 24 mm [18].
Chloroform extracts of Hagenia abyssinica (Bruce) JF Gmel showed that limited. The methanolic extracts of A. indica showed maximum inhibition of both Salmonella (70%) and Shigella (80%) isolates at a concentration of 2 mg/ml which is almost comparable with tetracycline. but methanolic and chloroform extracts up to a concentration of 1 mg/ml were not able to inhibit bacterial growth appreciably suggesting the probable variations between the organic solvents used that result in different extract profiles in terms of quality and quantity [26]. During the assessment, water extract does not show a zone of inhibition against those microorganisms. As Semeneh et al.,[24] stated that the antimicrobial activities of ethanol methanol chloroform and water extracts of Moringa stenopetala Leaves against Escherichia coli pathogens was 8mm, 12mm, 11.5mm, and 8mm respectively through disc diffusion method. According to Alemtshay [2] ethanol extract of Guizotia schimperi Sch. Bip. ex Walp. showed higher antibacterial activity for the test S. aureus ATCC 33591, ATCC 33592, SA3 and SA5 strains (128–256 μg/ml) than oxacillin (512μg/ml). Petroleum ether extract of seed of Nigella sativa exhibited activity against both the laboratory isolated and certified strain of Bacillus cereus. Zone of inhibition indicated that 44 ± 0.31 mm and 40 ± 2.33 mm respectively as mentioned by Ketema [13].
Enterococcus faecalis was reported as the etiology of endodontic failure. The methanolic extracts of Eucalyptus galbie and Myrtus communis L. had antibacterial activity against E. faecalis. The diameter of the inhibition zone was near 9.6 mm and 7.6 mm respectively [17]. Ethanolic extract of Origanum vulgare demonstrated lower cell viability than the aqueous extract and has significant antiviral activity against some viruses of veterinary importance Equine Arteritis Virus (EAV) and both aqueous and ethanolic extracts have antiviral action against Canine Distemper Virus (CDV) [5]. Methanolic extract of Rhizome coptidis inhibits the early viral entry steps of Hepatitis C Virus infection, which deserves further evaluation for use as an anti-HCV agent [27]. During the evaluation study, tested bacteria was influenced by the type of extraction solvent and other laboratory condition. Ultimately could have caused variation in the antimicrobial activity results. For example, Staphylococcus aureus growth in the presence of plant extract had inhibited already depends on the amount of dose, time of incubation and concentration of plant extracts [22]. Bioassay of 50% ethanol Ginkgo biloba leaf extracts had an 18.25 mm inhibition zone against Pseudomonas putida in vivo [8]. Antibiotics had associated with adverse impact on the host including hypersensitivity, and allergic reactions. Probably this paper might explain the use of these plants by the indigenous people against many infections for generations. Hagenia abyssinica (Bruce) JF Gmel traditionally used for antihelminthic activity especially Tape warm. It could be a pivotal role in antimicrobial discovery. In recent years many studies are focusing on natural products for the screening of new and potential antimicrobial agents [6]. Purified active antimicrobial compounds from Persicaria pensylvanica may serve as an alternative natural product to treat staphylococcal infections in humans and animals [22].
Synergistic interactions of phytochemicals and antibacterial drugs were advanced approaches to reduce drug resistance and toxicity. Phytochemical synergists are functional as inhibitors of active site modification, enzymes that degrade/modify drugs, and permeability enhancers/efflux pumps [19]. The formulation of the synergistic combination was accepted in the world. When C. zeylanicum extract was used in combination with azithromycin, it showed strong synergistic activity against P. gingivalis and T. denticola. A combination of C. zeylanicum with metronidazole and tetracycline showed synergistic outcomes against A. actinomycetemcomitans and P. gingivalis, respectively [25]. Rubus chingii extract combined with fluconazole showed significant synergy against fluconazole resistant Candida albicans [3].
The action of the aqueous and Ethanolic extract of Hagenia abyssinica (Bruce) JF Gmel was particularly interesting to tested organisms, as the microbes were almost partially inactivated in the presence of the extract when compared with the control. The mechanism of action of ethanolic extracts against Eshercial and Shiglla spp was not fully determined. It might be sourced from the antagonistic approach of extract leads to inhibiting biological potentiality.
Plant-derived extracts and essential compounds had demonstrated antibacterial activity via interfering in particular with the protein synthesis, enzymes inhibition, production of cell wall complexes, formation of disulfide bridges and intercalation with the cell wall and/or DNA [26]. It was known that antimicrobial action can vary to various microorganisms and even in different stages of infection; the action may be extracellular, in the adsorption to the cells, intracellular, during the replication or also in the stage of the liberation of the viral, and bacterial and fungal particles [12, 23]. Microbial diseases are a challenge for human health not only clinical severity but also financial losses. The application of antimicrobial drugs for prevention and treatment had characterized by several restrictions such as reduced action spectrum, limited therapeutic utility, microbial resistance, high costs, and limited availability. The emergence of Multidrug-Resistant (MDR) pathogens due to the irrational use of these agents, an increasing number of immune-compromised individuals, aging, transplant complications, and stress. The resistance mechanism is target site/receptor modification mediated via mutation in the target site which leads to a decline in the antimicrobial efficacy of drugs. Typical examples of this kind of resistance are structural alteration in the Penicillin- Binding Proteins (PBP) and mutations in DNA gyrase and RNA polymerase, which render several drugs inactive [14]. All study informants were publicized creating awareness and communitybased management and plantation programs urgently needed and give more emphasizes. Then, Ex-situ conservation was adopted for the implication of many years, genetic stability, distribution, commercialization, and other related work activities by authors. According to Marma [16], conservation of biodiversity considered as a strategy for improving human health and well-being. It helps to mitigate climate change, generating income, accessing and benefit-sharing. In addition to this, create new dimensions of sustainable agriculture and forestry (bio-innovations) also [1]. In Ethiopia, herbal practitioners actively engaged in crude preparations. Biruktayet [4] suggested that Hagenia abyssinica (Bruce) JF Gmel. were efficiently utilized and overexploited by rural communities of Bale, Kofele, and Debark, but not conserved even in agroforestry ways and urgently announced should be taken action.
Conclusion
Ethiopia has a long history of using medicinal plants for the treatment of various diseases. Hagenia abyssinica (Bruce) JF Gmel flower, ethanol extract showed that more effective than the leaf extract against S. flexneri which indicates 5mm and 2mm respectively. To generate socio-economic returns and to save the genetic resource conservation always implemented. All study key representatives had participated and give full informed consent about Ethno-medicine and its implications, but not included in this paper. The outcome presented in the above section was useful to the proposed idea inside of clinical researches. To end, this paper could serve as a preliminary source to motivate others for future exploration.
Recommendation
Further investigations should conduct to evaluate the efficacy of Hagenia abyssinica (Bruce) JF Gmel on anti- (viral, fungal, helminthic, cancerous, and diabetic) and other gram-negative and positive bacterial groups. Extra study is still needed as to the possible toxicity and mechanism of action through in vitro and in vivo bioassays. Evaluations in higher concentrations should apply to etiological agents may their active constituents have the potential to antimicrobial performance. Finally, it requires exploring the identification and characterization of phytochemical composition before more conclusions can be drawn.
Acknowledgment
We would like to thank all study participants for their unreserved involvement and providing samples. Next, Great gratitude goes to all staff members of Biotechnology for their constructive encouragement. Finally, thanks to Kotabe University for their support.
Data Availability
The data used to support the findings of this study are available from the corresponding author upon request.
References
- Abatenh E, Gizaw B (2018) Mushroom Preservation Protocol J Microbiol Biotechnol 3(1): 1-5.
- Teka A, Rondevaldova J, Asfaw Z, Demissew S, Van Damme P, et al. (2015) In vitro antimicrobial activity of plants used in traditional medicine in Gurage and Silti Zones, South Central Ethiopia. BMC Complementary and Alternative Medicine 15: 286).
- Han B, Chen J, Yu YQ, Cao YB, Jiang YY (2016) Antifungal activity of Rubus chingii extract combined with fluconazole against fluconazole-resistant Candida albicans Microbiol Immunol 60(2): 82-92.
- Assefa B, Glatzel G, Buchmann C (2010) Ethno-medicinal uses of Hagenia abyssinica (Bruce) JF Gmel. among rural communities of Ethiopia. Journal of Ethno biology and Ethno medicine 6(20): 1-10.
- Daiane Einhardt, Silvia de Oliveira Chemical Composition and Antiviral Effect of Extracts of Origanum vulgare, Advances in Bioscience and Biotechnology 10 (7): 188-196.
- Demain AL (2014) Importance of microbial natural products and the need to revitalize their discovery. J Ind Microbiol Biotechnol 41(2): 185-201.
- Fentahun M, Ayele Yilkal (2017) Antibacterial Evaluation and Phytochemical Analysis of Selected Medicinal Plants against Some Pathogenic Enteric Bacteria in Gozamin District, Ethiopia. J Pharmacovigil 5(5): ISSN: 2329-6887.
- Gangzheng Wang, Yuhua Gong (2016) Identification of and antimicrobial activity of plant extracts against Pseudomonas putida from rot fruiting bodies of Pleurotus eryngii. Scientia Horticulturae 212: 235-239.
- Gebregergs T, Biniam T (2015) In vitro Screening of Antibacterial Activities of Selected Ethiopian Medicinal Plants,” International Journal of Microbiological Research 6(1): 27-33.
- Gebru E, Gereziher G (2018) Determination of Antimicrobial Activity and Phytochemical Screening of Selected Medicinal Plants in Tigray region of Northern Ethiopia. Momona Ethiopian Journal of Science 10(2): 255-270.
- Gebremedhin Romha, Birhanu Admasu (2018) Antibacterial Activities of Five Medicinal Plants in Ethiopia against Some Human and Animal Pathogens. Evidence-Based Complementary and Alternative Medicine.
- Elshafie HS, Gruľová D, Baranová B, Caputo L, De Martino L, et al. (2019) Antimicrobial Activity and Chemical Composition of Essential Oil Extracted from Solidago canadensis L. Growing Wild in Slovakia. Molecules 24 (7): 1206.
- Ketema Bacha, Yinebeb Tariku, Gebreyesus F, Zerihun S, Mohammed A, et al. (2019) Antimicrobial and anti-Quorum Sensing activities of selected medicinal plants of Ethiopia: Implication for development of potent antimicrobial agents. BMC Microbiol 16(1): 139.
- Kumarasamy KK, Toleman MA, Walsh TR, Bagaria J, Butt F, et al. (2010) Emergence of a new antibiotic resistance mechanism in India, Pakistan, and the UK: a molecular, biological, and epidemiological study. Lancet Infect Dis 10(9): 597-602.
- Lou ZH, Wang LV, Wenping C, Ma Z (2010) Assessment of antibacterial activity of fractions from burdock leaf against food-related bacteria. Food Control 21: 1272-1278.
- Kilpatrick AM, Salkeld DJ, Titcomb G, Hahn MB (2017) Conservation of biodiversity as a strategy for improving human health and well-being, Philos Trans R Soc Lond B Biol Sci 372 (1722): 1-9.
- Raoof M, Khaleghi M, Siasar N, Mohannadalizadeh S, Haghani J, et al., (2019) Antimicrobial Activity of Methanolic Extracts of Myrtus Communis L. and Eucalyptus Galbie and their Combination with Calcium Hydroxide Powder against Enterococcus Faecalis. J Dent Shiraz Univ Med Sci 20(3): 195-202.
- Moe TS, Win HH, Hlaing TT, Lwin WW, Htet ZM, et al. (2018) Evaluation of in vitro antioxidant, antiglycation and antimicrobial potential of indigenous Myanmar medicinal plants. J Integr Med 16(5): 358-366.
- Ayaz M, Ullah F, Sadiq A, Ullah F, Ovais M, et al., (2019) Synergistic interactions of phytochemicals with antimicrobial agents: Potential strategy to counteract drug resistance. Chemico-Biological Interactions 308: 294-303.
- Nadro MS, AS Audu, E Glen (2018) Anti-diabetic Effects of Aqueous Extract and Oil of Moringa oleifera Seed on Liver and Kidney Functions in Streptozotocin-induced Diabetes in Rats. American Journal of Biochemistry 8(4): 69-74.
- Niguse A, Solomon Y (2016) Chemical Composition and Antibacterial Activity of Essential Oil of Callistemon citrinus from Ethiopia. European Journal of Medicinal Plants. 17(1): 1-7.
- Reta Duguma, Abdia B (2019) Antimicrobial activity of Persicaria pensylvanica extract against Staphylococcus aureus. European Journal of Integrative Medicine 29 (100921): 1-7.
- Schnitzler P, Nolkemper S (2008) Comparative In Vitro Study on the Anti-Herpetic Effect of Phytochemically Characterized Aqueous and Ethanolic Extracts of Salvia officinalis Grown at Two Different Locations. Phytomedicine 15: 62-70.
- Semeneh Seleshe, Suk Nam Kang (2019) In Vitro Antimicrobial Activity of Different Solvent Extracts from Moringa stenopetala Leaves. Prev Nutr Food Sci 24(1): 70-74.
- Saquib SA, AlQahtani NA, Ahmad I, Kader MA, Al Shahrani SS (2019) Evaluation and Comparison of Antibacterial E_cacy of Herbal Extracts in Combination with Antibiotics on Periodontal pathobionts: An in vitro Microbiological Study. Antibiotics 8(3): 89.
- Tesso H (2015) Antibacterial activity and phytochemical screening of some important medicinal plants against human diarrheal pathogens in Adama city, Ethiopia. International Journal of Microbiology and Immunology Research 3(3): 029-035.
- Hung TC, Jassey A, Lin CJ, Liu CH5, Lin CC, et al. (2018) Methanolic Extract of Rhizoma Coptidis Inhibits the Early Viral Entry Steps of Hepatitis C Virus Infection. Viruses 10(12): 669.

















